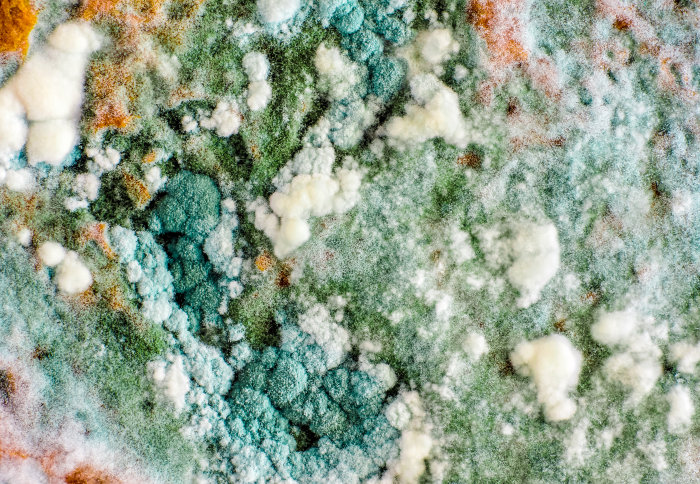
Плесень на стене текстура
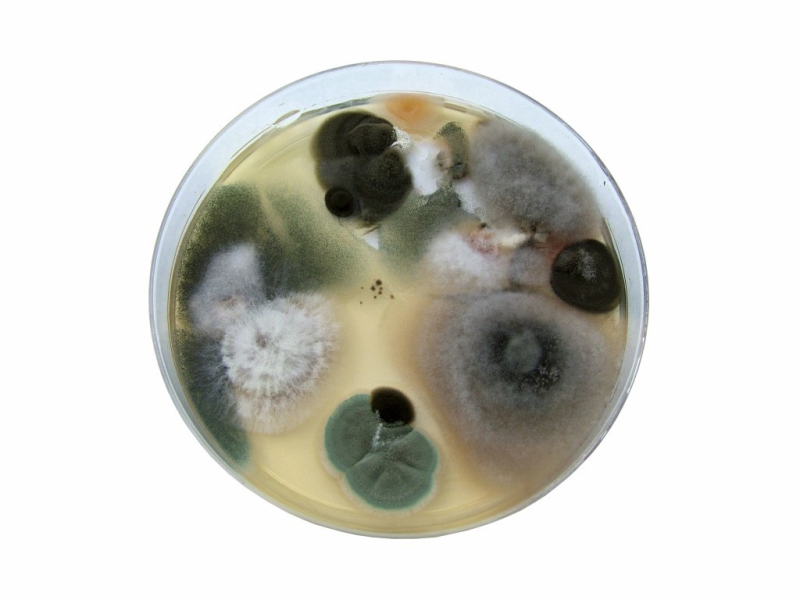
Плесневые грибы в чашке Петри

Плесень на прозрачном фоне может выглядеть как неприятное и опасное явление, которое портит продукты питания или поверхности. Это вид грибкового растения способен размножаться быстро и проникать внутрь материалов, что делает его трудным для удаления. Появление плесени на прозрачном фоне часто свидетельствует о недостаточной вентиляции, высокой влажности или загрязнении окружающей среды. Для избежания появления плесени необходимо регулярно проводить уборку и поддерживать оптимальный микроклимат в помещении.
![Плесень текстура]()
Плесень текстура
![Плесневые грибы на прозрачном фоне]()
Плесневые грибы на прозрачном фоне
Скачать
![Плесень на прозрачном фоне]()
Плесень на прозрачном фоне
Скачать
![Текстура грязи на стене]()
Текстура грязи на стене
Скачать
![Стены плесень фактуры]()
Стены плесень фактуры
Скачать
![Плесень на стене текстура]()
Плесень на стене текстура
Скачать
![Плесень на прозрачном фоне]()
Плесень на прозрачном фоне
![Плесень текстура]()
Плесень текстура
![Плесень в чашке Петри]()
Плесень в чашке Петри
![Плесень и грибок на стенах]()
Плесень и грибок на стенах
Скачать
![Плесени/плесневые грибы]()
Плесени/плесневые грибы
Скачать
![Плесневые грибки]()
Плесневые грибки
Скачать
![Плесень на стене текстура]()
Плесень на стене текстура
![Плесень текстура]()
Плесень текстура
![Плесень фактура]()
Плесень фактура
![Черная плесень аспергилл черный]()
Черная плесень аспергилл черный
![Плесень для фотошопа]()
Плесень для фотошопа
Скачать
![Плесень на прозрачном фоне]()
Плесень на прозрачном фоне
![Плесневые грибы в чашке Петри]()
Плесневые грибы в чашке Петри
Скачать
![Плесень текстура]()
Плесень текстура
![Плесень на стене текстура]()
Плесень на стене текстура
Скачать
![Плесень фактура]()
Плесень фактура
Скачать
![Плесень вектор]()
Плесень вектор
Скачать
![Плесень для фотошопа]()
Плесень для фотошопа
Скачать
![Текстура пятен плесени]()
Текстура пятен плесени
Смотрите онлайн или можете скачать на телефон или компьютер в хорошем качестве совешенно бесплатно. Не забывайте оставить комментарий и посмотреть другие фотографии и изображения высокого качества, например плетка и пифагор из раздела картинки

Grizly.club
Grizly.club